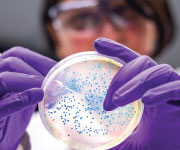
computer illustration of human heart

Probiotic-Phage Blend Fights Digestive Problems and Boosts Immune Defenses
Taking probiotics combined with bacteriophages ease gastrointestinal distress. This allows beneficial bacteria to flourish stronger to boost digestion and immunity.
By Michael Downey, Health & Wellness Author.

Gas. Bloating. Stomach pain. Diarrhea.
As many as 74% of Americans suffer from these and similar digestive problems.1
Up to 15% of U.S. adults live with chronic irritable bowel syndrome.2
An underlying cause of many of these conditions is an imbalance of good to bad bacteria in our gut.3-5
Health-conscious people know the value of taking a quality probiotic. These healthpromoting bacteria help rebalance the gut microbiota.
Now there is a way to make probiotics even more powerful and more effective.
Research shows that when 7 specific probiotics and 4 types of bacteriophages are used in combination, harmful bacteria are reduced, allowing beneficial bacteria to grow to as many as thousands of times their baseline rate.6,7
Bacteriophages are tiny packages of DNA or RNA wrapped in protein that seek out and selectively eliminate only harmful bacteria.8 This encourages healthybacteria to rapidly multiply and thrive.
Combining probiotics and bacteriophages in a protective dual-encapsulation format provides an innovative solution for digestive and overall systemic health.

WHAT YOU NEED TO KNOW
Upgrade Probiotics with Bacteriophages
- An imbalance in our gut bacteria is a cause of digestive problems like bloating, gas, and diarrhea.
- Taking probiotics, beneficial bacteria, can fix that imbalance and dramatically ease gastrointestinal distress.
- Scientists have developed a way to make probiotics far more effective: combining them with bacteriophages, packages of DNA or RNA wrapped in protein.
- These “phages” selectively target and eliminate only undesirable bacteria while encouraging beneficial probiotic organisms to flourish.
- Researchers have now identified seven specific probiotic strains that improve digestive health and increase their populations by an average of 30 times when taken with a unique four-bacteriophage blend.
- Scientists have combined these seven strains and the phage blend in a dual-encapsulation form that ensures they survive the harsh stomach environment and populate the gut.
The Importance of a Healthy Microbiome
The gut microbiota—the trillions of microorganisms in the gastrointestinal tract9—play a critical role in health and disease.
The balance of good to bad bacteria can be disrupted by age, medication, stress, or a diet heavy in processed carbohydrates, meats, fats, preservatives, and other additives.3,10,11
Antibiotic overuse also wreaks havoc on the gut microbiota, killing both bad and healthy bacteria.12,13
An imbalance in the ratio of good to bad bacteria can trigger the development of digestive problems like gas, diarrhea, bloating, and stomach pain.
It can also lead to irritable bowel syndrome, a chronic condition causing these and other symptoms, including cramping and constipation.
The solution is to shift your gut microbiota toward a healthy balance, which can resolve digestive issues and improve overall health.9
Giving Probiotics a Boost
Oral probiotics have proven an effective way to increase levels of beneficial bacteria.14
But they can have difficulty competing with the more aggressive, harmful microbes in the gut.
Scientists have found a way to give probiotics a huge advantage: combining the probiotics with a technique known as phage therapy.
This approach uses bacteriophages, or phages for short, to selectively reduce only harmful bacteria.
That clears the way for beneficial probiotic organisms to flourish and more fully restore the microbiome to a healthy, balanced state.15
What exactly are bacteriophages?
They’re submicroscopic packages of DNA or RNA enclosed in a protein envelope.8 Each one is chosen for its targeted ability to attach to a particular strain of unwanted bacteria (like E. Coli) in the intestines.
Safety Profile
Bacteriophages are found almost everywhere—from soil, hot springs, and the ocean depths, to the animal and human body.37
They have been successfully and safely used in numerous human clinical and therapeutic settings.38-40
In fact, phage therapy has been used to treat infections of the gastrointestinal tract, skin, head and neck, bone, chest, and abdomen.16,38,41
And they have successfully targeted disease-causing bacteria such as Staphylococcus, Streptococcus, E. coli, Salmonella, and Pseudomonas.16,38,41
Evidence suggests that success rates for phage therapy may range up to 80% to 95% with either no side effects, or only mild and reversible ones.16,38,41
Together with probiotics, which also have a long history of safe use, they’re a powerful way to promote digestive health.
The Origins of Phage Therapy
Phage therapy has a long history.
Scientists pioneered the use of bacteriophages in Eastern Europe before World War I.8,16,17
By the 1940s, corporations such as Eli Lilly and L’Oréal had developed bacteriophage “cocktails” as a highly effective treatment for infections.18
The development of powerful antibiotics soon pushed this approach into the background.
But antibiotics eliminate both harmful and healthy bacteria, leaving us vulnerable to attack by other organisms.19 Bacteriophages eliminate only detrimental bacteria.
Recognizing bacteriophages’ targeted activity, the food industry now uses them to reduce dangerous bacteria, from Listeria to E. coli to Salmonella.20-22
Taken orally, phages provide protection both in the large intestine, where bacterial imbalance occurs, and in the small intestine, where bacterial overgrowth can occur. They are effective in small doses and work within hours.6
By combining probiotics and phage therapy, scientists have documented an exponential increase in beneficial bacteria and a similar decrease in harmful bacteria.23-25
Cell-Based Studies
Researchers demonstrated the effectiveness of a specific mix of four bacteriophages in studies using E. coli bacteria.
E. coli (Escherichia coli) can cause diarrhea, urinary tract infections, pneumonia, and other illnesses,26 and crowd out beneficial organisms.
The researchers cultured healthy Bifidobacterium longum in two Petri dishes along with E. coli. A bacteriophage mixture was added to just one dish.6
Five hours later, there was little growth of B. longum in the dish without bacteriophages. This health-promoting strain (B. longum) could not compete with E. coli.6
But in the dish also containing bacteriophages, B. longum colonies rocketed to more than 7,000 times the numbers compared to those in the untreated (without phages) dish.6
The bacteriophages had selectively targeted and eliminated E. coli, making room for the beneficial B. longum bacteria to multiply.
Scientists conducted the same experiment using beneficial Lactobacillus acidophilus instead of B. longum.
Again, the E. coli suppressed growth of L. acidophilus in the untreated culture. But in the Petri dish containing bacteriophages, L. acidophilus colony counts were 20-fold higher than in the other culture.6
The beneficial Bifidobacterium bifidum bacteria combined with bacteriophages also showed impressive results.6
To further validate these findings, scientists moved on to laboratory animals.

How Bacteriophages Differ from Antibiotics
Antibiotics are one of the 20th century’s greatest scientific discoveries.
But decades of widespread antibiotic use have created “superbugs” that are largely resistant to current antibiotics.
In severe cases, physicians desperately search for alternatives to save patients’ lives.
This has prompted excitement about bacteriophages.
Eastern European doctors were successfully neutralizing bacterial infections with phage therapy, a treatment aimed at selectively targeting and destroying harmful bacteria.
With the rise in antibiotic-resistant bacteria, phage therapy is experiencing a revival in the scientific community because of its effectiveness and safety.
Phage cocktails have been shown to effectively treat common bacterial invaders, including staph, strep, and E. coli.23-25
Phage therapy also encourages growth of healthy bacteria in the gut microbiome, which can further reduce harmful bacteria.
Animal Studies
The probiotic B. longum was given to a group of mice, along with a disease-causing E. coli strain. A second group received the same mixture plus the phage blend specifically designed to target E. coli.7
Just 24 hours later, the phage-treated mice had:7
- About a 10-fold decrease in E. coli in the small intestine,
- About a 100-fold decrease in E. coli in the large intestine, and
- About a 100-fold decrease in E. coli in fecal matter.
The phage-treated group also had:7
- About a 100-fold increase in B. longum in the small intestine,
- About a 100-fold increase in B. longum in the large intestine, and
- About a 40-fold increase in B. longum in fecal matter.
This translated into clear benefits: Phage-treated mice had improved digestive function with no detrimental side effects.
By contrast, mice treated only with E. coli and B. longum, without the added phages, became constipated. Intestinal segments showed swelling, redness, and leaks.7
As a result of these and other studies, scientists have begun adding bacteriophages to probiotics to make a more effective, enhanced probiotic formula.
Probiotic Strains Boosted by Phages
Recent research has identified seven specific probiotic strains that have two important benefits for digestive health:
- Each probiotic is documented to improve an array of digestive symptoms.4,5,27-35
- Each probiotic’s colony numbers are greatly increased when taken with a carefully developed bacteriophage mix.7
The seven strains in this probiotic blend are enhanced by an average of 30 times when combined with the mix of four bacteriophages.36
Every single one of these probiotics has been shown in studies to improve irritable bowel syndrome.5,27-31
They’ve also demonstrated the ability to benefit an array of other gastrointestinal issues:
- B. longum SP54, L. paracasei IMC502, and L. rhamnosus IMC501 provide antimicrobial effects against Candida (an infection-causing fungus), H. pylori (bacteria that can cause ulcers), and E. coli.27,32,34
- B. lactis BLC1 and L. acidophilus LA1 relieve symptoms of ulcerative colitis (a disease that causes inflammation and ulcers in the colon)33 and ease lactose intolerance.35
- B. breve Bbr8 and L. plantarum 14D reduce symptoms of celiac disease, which can include diarrhea, bloating, and gas.4,5
Researchers have combined these seven specific probiotic strains with the bacteriophage blend for comprehensive gut health.
Because not all commercial probiotics reach their intended target, a dual-encapsulation format was developed.
By protecting the beneficial bacteria from stomach acids that would otherwise destroy them, this more effectively promotes healthy intestinal colonization.

Probiotics Defend Against Viral Infections of the Respiratory Tract
It may come as a surprise that consuming beneficial probiotic bacteria could have a beneficial effect on the respiratory tract and viral illnesses. There is a strong connection between gut flora and protection of the respiratory tract from viruses.
The connection exists because both the intestinal and respiratory mucosa have similar characteristics and structures.
The mucosa is the primary site where most common viruses—including those that cause the common cold, flu, and new coronavirus—gain entry into the body. For this reason, they can be considered the “front lines” of the battle against many viral illnesses.
Ideally, the mucosa of the digestive and respiratory tracts is protected from infection by a number of reinforcements. Collectively known as the mucosal defense system, these help to keep potentially harmful viruses and bacteria at bay while allowing healthy probiotics to thrive.
Unfortunately, these defense systems are not always in top form and cannot prevent all infectious illnesses. This is particularly true with advancing age, when mucosal immunosenescence leads to waning mucosal defenses, making viral illnesses more likely and potentially more dangerous.42 Other chronic diseases that weaken immune defenses can further compound the problem. Fortunately, we can do something about it.
Research has revealed that probiotics stimulate and boost mucosal defenses, both for the gastrointestinal and respiratory systems.43-46 While many of the probiotic organisms consumed may end up in the gut, some colonize parts of the respiratory tract as well.47 The mucosal defense systems get activated by these healthy organisms, guarding against real threats, including viruses.
In addition, healthy bacteria in probiotic foods and supplements help amplify general systemic immune functions as well, getting the body ready to fight off infection more effectively should one occur.
These two effects of probiotics—shielding the mucosa and boosting immune function—work together to both decrease the incidence of viral infections and to reduce their severity if they do occur. This effect has been demonstrated in human clinical trials.
Several small studies have found that probiotics have beneficial effects against respiratory tract infections.44,46 A recent review of the existing literature concluded that probiotics had a positive influence on several outcome measures.44 In addition to reducing the total number of respiratory tract infections, they also reduced the average length of illness, use of antibiotics, and school absences, in cases where viral outbreaks occur.
One study evaluated a blend of probiotics that includes some of the very same bacterial species discussed in this article, B. lactis, L. plantarum, and L. rhamnosus.48 The study scientists randomized 250 healthy adults to receive this probiotic blend or a placebo daily for 90 days during peak flu season.
The impact this probiotic treatment had on respiratory infections was not subtle! The number of flu and flu-like viral illnesses were reduced by an impressive 75%. The rate of colds—also a viral illness—was also reduced, by 39%.
In the small number of subjects on the probiotic supplement who did get sick, probiotics still had a beneficial impact, reducing both the severity and duration of viral illness. Symptom severity in flu was reduced by 37%.
The length of illness was also reduced, by about one day on average for colds, three days for cough, and close to one-and-a-half days for all acute upper respiratory tract infections overall.
With respiratory tract viral illness—from common cold and flu to new threats on the rise, probiotic supplementation may provide an added layer of protection from infection.
In addition to standard precautions such as hand washing and avoiding contact with sick individuals, probiotic supplements may help to reduce viral illness risk and severity by bolstering mucosal defenses and general immune function.
Summary
Many digestive problems, like diarrhea, gas, and stomach pain, are caused by an imbalance in the gut microbiome.
Probiotics can correct this imbalance, improving gastrointestinal comfort and overall health.
Taking probiotics with bacteriophages, which target and eliminate only unhealthy microbes, allows beneficial bacteria to multiply at a vastly greater rate.
Scientists have identified seven specific probiotic strains that improve digestive symptoms and boost their intestinal colonies by an average of 30 times when taken with a specific blend of four bacteriophages.
A unique dual-encapsulation process protects these probiotics from stomach acids that would otherwise destroy them, enabling them to make it to the gut and thrive.
As you’ll see on the next page, probiotics have also demonstrated anti-viral properties by enhancing immune defenses.
If you have any questions on the scientific content of this article, please call a Life Extension® Wellness Specialist at 1-866-864-3027.
References
- Available at: https://www.foxnews.com/health/survey-shows-74-percent-of-americans-living-with-gi-discomfort. Accessed February 4, 2020.
- Available at: https://gi.org/topics/common-gi-symptoms/. Accessed February 4, 2020.
- Brown K, DeCoffe D, Molcan E, et al. Diet-induced dysbiosis of the intestinal microbiota and the effects on immunity and disease. Nutrients. 2012 Aug;4(8):1095-119.
- Cristofori F, Indrio F, Miniello VL, et al. Probiotics in Celiac Disease. Nutrients. 2018 Nov 23;10(12).
- Francavilla R, Piccolo M, Francavilla A, et al. Clinical and Microbiological Effect of a Multispecies Probiotic Supplementation in Celiac Patients With Persistent IBS-type Symptoms: A Randomized, Double-Blind, Placebo-controlled, Multicenter Trial. J Clin Gastroenterol. 2019 Mar;53(3):e117-e25.
- Supplier Internal Study. A Probiotic-Enhancing Prebiotic. Data on File. 2016.
- Supplier Internal Study. Bacteriophage Cocktail Mice Clinical TrialsData on File. 2016.
- Pelfrene E, Willebrand E, Cavaleiro Sanches A, et al. Bacteriophage therapy: a regulatory perspective. J Antimicrob Chemother. 2016 Aug;71(8):2071-4.
- Khanna S, Tosh PK. A clinician’s primer on the role of the microbiome in human health and disease. Mayo Clin Proc. 2014 Jan;89(1):107-14.
- Pendyala S, Walker JM, Holt PR. A high-fat diet is associated with endotoxemia that originates from the gut. Gastroenterology. 2012 May;142(5):1100-1 e2.
- Van den Abbeele P, Verstraete W, El Aidy S, et al. Prebiotics, faecal transplants and microbial network units to stimulate biodiversity of the human gut microbiome. Microb Biotechnol. 2013 Jul;6(4):335-40.
- Francino MP. Antibiotics and the Human Gut Microbiome: Dysbioses and Accumulation of Resistances. Front Microbiol. 2015;6:1543.
- Watkins RR, Bonomo RA. Overview: Global and Local Impact of Antibiotic Resistance. Infect Dis Clin North Am. 2016 Jun;30(2):313-22.
- Azad MAK, Sarker M, Li T, et al. Probiotic Species in the Modulation of Gut Microbiota: An Overview. Biomed Res Int. 2018;2018:9478630.
- Mimee M, Citorik RJ, Lu TK. Microbiome therapeutics - Advances and challenges. Adv Drug Deliv Rev. 2016 Oct 1;105(Pt A):44-54.
- Abedon ST, Kuhl SJ, Blasdel BG, et al. Phage treatment of human infections. Bacteriophage. 2011 Mar;1(2):66-85.
- Bruynoghe R, and J. Maisin. Essais de thérapeutique au moyen du bacteriophage. C. R. Soc. Biol. 1921;85:1120-1.
- Moelling K, Broecker F, Willy C. A Wake-Up Call: We Need Phage Therapy Now. Viruses. 2018 Dec 5;10(12):688.
- Chan BK, Abedon ST, Loc-Carrillo C. Phage cocktails and the future of phage therapy. Future Microbiol. 2013 Jun;8(6):769-83.
- Garcia P, Martinez B, Obeso JM, et al. Bacteriophages and their application in food safety. Lett Appl Microbiol. 2008 Dec;47(6):479-85.
- Sillankorva SM, Oliveira H, Azeredo J. Bacteriophages and their role in food safety. Int J Microbiol. 2012;2012:863945.
- Woolston J, Parks AR, Abuladze T, et al. Bacteriophages lytic for Salmonella rapidly reduce Salmonella contamination on glass and stainless steel surfaces. Bacteriophage. 2013 Jul 1;3(3):e25697.
- Chibeu A, Lingohr EJ, Masson L, et al. Bacteriophages with the ability to degrade uropathogenic Escherichia coli biofilms. Viruses. 2012 Apr;4(4):471-87.
- Dalmasso M, de Haas E, Neve H, et al. Isolation of a Novel Phage with Activity against Streptococcus mutans Biofilms. PLoS One. 2015;10(9):e0138651.
- Kazmierczak Z, Gorski A, Dabrowska K. Facing antibiotic resistance: Staphylococcus aureus phages as a medical tool. Viruses. 2014 Jul 1;6(7):2551-70.
- Available at: https://www.cdc.gov/ecoli/general/index.html. Accessed February 4, 2020.
- Verdenelli MC, Silvi S, Cecchini C, et al. Influence of a combination of two potential probiotic strains, Lactobacillus rhamnosus IMC 501(R) and Lactobacillus paracasei IMC 502(R) on bowel habits of healthy adults. Lett Appl Microbiol. 2011 Jun;52(6):596-602.
- Alm L, Ryd-Kjellen E, Setterberg G, et al. Effect of a new fermented milk product ‘CULTURA’on constipation in geriatric patients. Paper presented at: 1st Lactic Acid Bacteria Computer Conference Proceedings. Horizon Scientific Press, Norfolk, England1993.
- Black F, Andersen P, Ørskov J, et al. Prophylactic efficacy of lactobacilli on traveler’s diarrhea. Travel Medicine: Springer; 1989:333-5.
- Silvi S, Verdenelli MC, Cecchini C, et al. Probiotic-enriched foods and dietary supplement containing SYNBIO positively affects bowel habits in healthy adults: an assessment using standard statistical analysis and Support Vector Machines. Int J Food Sci Nutr. 2014 Dec;65(8):994-1002.
- Yaeshima T, Takahashi S, Matsumoto N, et al. Effect of Yogurt Containing Bifidobacterium longum BB536 on the Intestinal Environment, Fecal Characteristics and Defecation Frequenc. 1997;16(2):73-7.
- Coman MM, Verdenelli MC, Cecchini C, et al. In vitro evaluation of antimicrobial activity of Lactobacillus rhamnosus IMC 501((R)), Lactobacillus paracasei IMC 502((R)) and SYNBIO((R)) againstpathogens. J Appl Microbiol. 2014 Aug;117(2):518-27.
- Laake KO, Bjorneklett A, Aamodt G, et al. Outcome of four weeks’ intervention with probiotics on symptoms and endoscopic appearance after surgical reconstruction with a J-configurated ileal-pouch-anal-anastomosis in ulcerative colitis. Scand J Gastroenterol. 2005 Jan;40(1):43-51.
- Namba K, Yaeshima T, Ishibashi N, et al. Inhibitory Effects ofBifidobacterium longumon EnterohemorrhagicEscherichia coliO157: H7. 2003;22(3):85-91.
- Virta PJER, Pharmacia, Finland. The Effect of a Preparation Containing Freeze-Dried Lactic Acid Bacteria [L. acidophilus LA-5 (LA-1) and Bifidobacterium TB-12] on Lactose Intolerance. 1993.
- Unpublished Internal Data Provided by Deerland. 2020.
- Dabrowska K, Switala-Jelen K, Opolski A, et al. Bacteriophage penetration in vertebrates. J Appl Microbiol. 2005;98(1):7-13.
- Sarker SA, McCallin S, Barretto C, et al. Oral T4-like phage cocktail application to healthy adult volunteers from Bangladesh. Virology. 2012 Dec 20;434(2):222-32.
- Bruttin A, Brussow H. Human volunteers receiving Escherichia coli phage T4 orally: a safety test of phage therapy. Antimicrob Agents Chemother. 2005 Jul;49(7):2874-8.
- McCallin S, Alam Sarker S, Barretto C, et al. Safety analysis of a Russian phage cocktail: from metagenomic analysis to oral application in healthy human subjects. Virology. 2013 Sep 1;443(2):187-96.
- Alisky J, Iczkowski K, Rapoport A, et al. Bacteriophages show promise as antimicrobial agents. J Infect. 1998 Jan;36(1):5-15.
- Fujihashi K, Kiyono H. Mucosal immunosenescence: new developments and vaccines to control infectious diseases. Trends Immunol. 2009 Jul;30(7):334-43.
- Forsythe P. Probiotics and lung diseases. Chest. 2011 Apr;139(4):901-8.
- Hao Q, Dong BR, Wu T. Probiotics for preventing acute upper respiratory tract infections. Cochrane Database Syst Rev. 2015 Feb 3(2):CD006895.
- Isolauri E, Sutas Y, Kankaanpaa P, et al. Probiotics: effects on immunity. Am J Clin Nutr. 2001 Feb;73(2 Suppl):444S-50S.
- Lehtoranta L, Pitkaranta A, Korpela R. Probiotics in respiratory virus infections. Eur J Clin Microbiol Infect Dis. 2014 Aug;33(8):1289-302.
- Tapiovaara L, Lehtoranta L, Swanljung E, et al. Lactobacillus rhamnosus GG in the middle ear after randomized, double-blind, placebo-controlled oral administration. Int J Pediatr Otorhinolaryngol. 2014 Oct;78(10):1637-41.
- Pregliasco F, Anselmi G, Fonte L, et al. A new chance of preventing winter diseases by the administration of synbiotic formulations. J Clin Gastroenterol. 2008 Sep;42 Suppl 3 Pt 2:S224-33.


